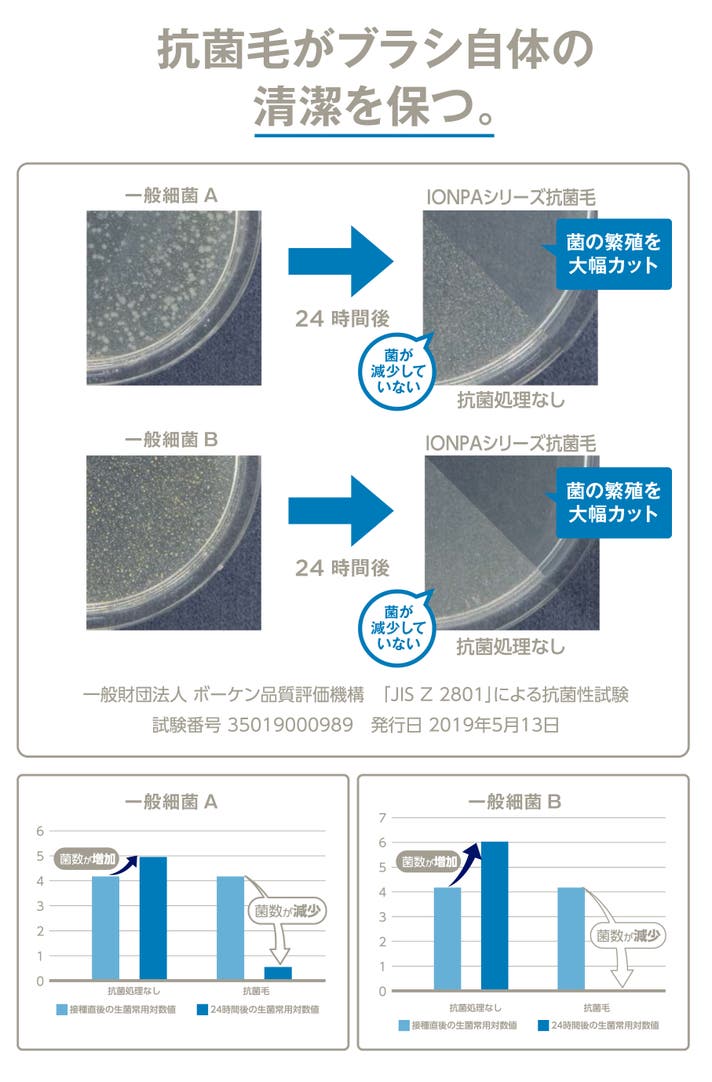

プロジェクト実行者
ストーリー
- 【マイナスイオン×音波振動で歯垢を落としやすく】東京医科歯科大で実証された科学のチカラ
- 【動かしても大丈夫な電動歯ブラシ】優しい振動でもしっかり歯垢を除去。“手磨き派”のあなたにこそ
- 【手軽に使える「ちょうどいい」設計】高機能はそのままに無駄を省いた、ミニマルでリーズナブル









そんな理由から、電動に切り替えられない方や、手磨きに戻ってしまう方も少なくありません。
実際、日本での電動歯ブラシ普及率はまだ約2割程度。
一方、歯科医療先進国といわれるスウェーデンをはじめとしたヨーロッパでは、比較的高い普及率を示しています。


私たちアイオニック株式会社は、40年以上にわたり“イオンの力”に着目し、イオン歯ブラシの開発・販売を続けてきました。
日本で早期からその実用化に取り組んできた私たちが、本当に必要な機能だけにこだわって開発したのが、【IONPA充電式 新モデル】です。

日々、歯ブラシに携わっている中で聞こえるそんな“皆さまの声”を反映した【IONPA充電式新モデル】は、
・マイナスイオン×音波振動で歯垢をゆるめて落としやすく
・最大35,000ストロークで、すみずみまでしっかりアプローチ
・目的に合わせて使い分けられる4つのブラッシングモード
・30秒ごとのお知らせタイマー機能付きでむらなく均等に
毎日使いたくなる“ちょうどいい1本”に仕上げました。

朝2分、夜2分の新習慣。
IONPAを使うひとときが、“整う習慣”と“実感できるケア”へ変わります。
高機能で、見た目はすっきりスマート。
リーズナブルだから、毎日気兼ねなく使える。
お手頃価格&豊富な替えブラシで、続けやすい。
そんな1本が手に入ることで、自分のケアに満足できる毎日が始まります。

IONPAは、イオン歯ブラシを長年使い続けている方や、患者の歯周ケアをサポートするプロフェッショナルからも高い評価を獲得。
「継続しやすく、効果も実感できる」と太鼓判をいただいています。

歯垢は歯の表面に付着しやすく、通常のブラッシングだけでは落としにくいことがあります。【IONPA充電式 新モデル】は、音波振動と毛先から発生する微弱な電流を組み合わせることで、歯と歯垢の結びつきをゆるめ、浮かせて落としやすくします。その結果、自社手磨き用歯ブラシとの比較で歯垢除去率196%を確認しました(※1)。
毎日のブラッシングをサポートし、すっきりとした磨き上がりを目指せます。
※1 イオンの発生しない自社手磨き用歯ブラシとの比較(大臼歯の隣接面において)※マイナスイオンとは、使用時に把持部とブラシ部に電位差が生じ、人体を導体として回路が閉じることで、ブラシから発生する微弱な電流を指します。



本体背面(導電性樹脂)に触れると体が導電体となり、口に入れることで回路がつながり、マイナスイオンが発生します。

イオンと音波振動のWパワーで、歯垢が溜まりやすい大臼歯の隣接面において、手磨き用歯ブラシと比較して196%の歯垢除去率が確認されています。
※イオンの発生しない自社手磨き用歯ブラシとの比較(大臼歯の隣接面において)

【IONPA充電式 新モデル】では、22,000~35,000ストロークの音波振動を搭載した4つのブラッシングモード。
手磨きのようについ手を動かしてしまう...
手磨きのように動かして「磨いた!!」を実感したい...
そんな方にぴったりな、やさしい22,000ストロークの「Sensitive」モードをご用意。マイナスイオン×音波振動の働きで歯垢を浮かせるため、22,000ストロークでも「歯と歯の隙間の汚れ」までやさしくケアできます。

「強すぎて不安」「合わなくて使わなくなる」
そんな電動歯ブラシの“よくある悩み”を、選べるモードで解消。使う人に寄り添う、やさしくて頼れる1本に仕上げました。

【IONPA充電式 新モデル】は、30秒ごとに振動でお知らせするタイマー機能を搭載。
2分ごとに短く3回振動し、リズムよく正しいペースを意識できます。
使うたびに磨き方のバランスが整い、毎日のケアが“整った習慣”になります。

IPX7相当の防水仕様で、使用後はまるごと水洗いできるからお手入れもラク。
清潔に保ちやすく、洗面所でもお風呂場でも、ストレスなく続けられるのが特長です。
「面倒で使わなくなる」「なんとなくサボりがち」そんな悩みからも卒業できます。

【IONPA充電式 新モデル】は、毎日手に取る前提で、使いやすさを徹底的に設計。
直径わずか約6cmの専用スタンドは、洗面台のすみにもすっきり収まり、場所をとりません。
コンパクトでストレスフリーだから、自然と続けたくなる1本です。

スリムで握りやすい本体に、USB対応の高性能バッテリーを搭載。
フル充電(約4時間)で、1日2回の使用でもおよそ25日使える設計です。
こまめな充電の手間を減らし、“続けやすさ”にこだわりました。

「替えブラシが高くて続けにくい」「どれを選べばいいかわからない」
IONPAは、そんな悩みにしっかり向き合いました。
目的に合わせて選べる複数タイプを用意。
替えブラシはドラッグストアやネットでも購入できるので、無理なく、気軽に続けられます。

累計3億本の販売実績を誇るIONICのイオン歯ブラシ・電動歯ブラシで使用されている専用替えブラシに対応。
全国で手に入りやすく、経済的にも続けやすいのが特長です。

替えブラシには、抗菌加工を施した毛材を採用しています。
日常的な使用における衛生面に配慮された設計で、菌の繁殖を抑えることが確認された素材を使用しています。
※抗菌性試験は第三者機関にて実施済(試験方法:JIS Z2801 準拠)

私たちアイオニック株式会社は千葉県・流山市に本社を構え、1970年代から“イオンの力”に着目し、イオン歯ブラシの研究・実用化にいち早く取り組んできたメーカーです。
以来40年以上、歯と口の健康を支え続けてきた経験を生かし、「毎日の歯みがきをもっと快適に、もっと安心に」を追求してきました。
そして今回、「こうだったらいいのに」という声を形にし、ゼロから設計し直したのが、このIONPA新モデルです。
忙しい朝も、眠たい夜も。あなたの毎日に寄り添う“40年の答え”を、ぜひ体験してください。

イオンの力と音波振動、それぞれの特性を活かしながら、“毎日心地よく使えるバランス”を追求。幾度もの試作と検証を重ねてきました。

特に「しっかり落とす力」と「やさしい磨き心地」の両立には時間をかけ、モードごとに最適な調整を実施。毎日のケアを無理なく続けられるよう工夫しています。

本製品は、日本国内で設計を行い、電動歯ブラシ本体の製造は提携する海外工場にて対応。
その後、国内で製造した専用ブラシをセットし、最終的な組立・検品・梱包までを国内で行っています。

毎日お使いいただくものだからこそ、品質には一切の妥協をせず。製品ごとに目視と手作業で丁寧にチェックし、清潔な環境で一つひとつ大切に仕上げています。

さらに、お問い合わせやアフターサポートもすべて国内で対応。ご購入後も、いつでも安心してご利用いただけます。

私たちが目指したのは、毎日の暮らしに自然になじむ“ちょうどいい”電動歯ブラシです。
電動ブラシが初めての方にも、しっかりケアしたい方にも、安心して気軽にお使いいただける1本に仕上げました。




ご購入前について
Q. 替えブラシはどこで購入できますか?
A. 市販のKISS YOUシリーズの替えブラシと互換性があり、全国のドラッグストアや自社ECサイトでお求めいただけます。
Q. 海外でも使用できますか?
A. はい、USB給電(DC5V)対応のため、変換アダプターをご使用いただければ海外でもご利用いただけます。
※電圧が異なる国では、対応アダプターをご確認ください。
ご使用について
Q. どのモードを選べばいいかわかりません。
A. 初めての方や刺激が気になる方には「Sensitive(やさしく)」がおすすめです。慣れてきたら「Clean」や「White」モードもお試しください。
Q. 濡れた状態で使用しても大丈夫ですか?
A. はい、防水仕様(IPX7)ですので、洗面所やシャワー使用にも対応しています。
※使用後はしっかり水を切り、風通しのよい場所で乾燥させてください。
Q. 充電はどのくらい持ちますか?
A. 約4時間でフル充電され、1日2回の使用で約25日間ご使用いただけます。
※使用状況により前後します。
Q. ペースメーカーを使用していますが、音波振動歯ブラシを使用しても大丈夫ですか。
A. ペースメーカーをご使用の方は念のためかかりつけの医師にご相談ください。
トラブル・不具合について
Q. 初期不良や動作不良があった場合はどうすればいいですか?
A. 商品到着後に不具合が見つかった場合は、サポート窓口(メール:info@ionic.co.jp 電話:0120-186-487)までご連絡下さい。初期不良は保証対象です。
Q. 使用中に動作しなくなった場合は?
A. まずは充電状態をご確認ください。それでも改善されない場合は、サポート窓口(メール:info@ionic.co.jp 電話:0120-186-487)までご連絡下さい。保証期間内(ご購入から1年間)の自然故障については無償で対応いたします。
Q. 替えブラシの交換頻度はどれくらいですか?
A. 目安として1〜2か月ごとの交換をおすすめしています。使用頻度やブラシの状態に応じて調整ください。

リスク&チャレンジ
※開発中の製品につきましては、デザイン・仕様が一部変更になる可能性もございます。 ※本文中に記載させていただいたスケジュールは、あくまでプロジェクト公開時点の予定です。応援購入の性質上、使用部材の供給状況、製造工程上の都合等により配送遅延の可能性もございます。原則として、配送遅延に伴う応援購入のキャンセルはできませんが、リターン配送予定月から3ヵ月を超えた場合には、希望者に限りキャンセルにて対応させていただきます。 ※本プロジェクトを通して想定を上回る皆様から応援購入を頂き、現在進めている環境から量産体制を更に整えることができた場合、正規販売価格が販売予定価格より下がる可能性もございます。
サポーターからの応援コメント
文章のトップに戻る
応援購入する
このプロジェクトはAll in型です。目標金額の達成に関わらず、プロジェクト終了日の2025年11月24日までに支払いを完了した時点で購入が成立します。
決済時に安心システム利用料として2.2%(税抜)がかかります。
インボイス(適格請求書):対応可
【通常販売】イオン電動歯ブラシIONPA
11,000円(税込)
■イオン電動歯ブラシIONPA × 1台
・本体×1
・専用スタンド×1
・ブラシ(抗菌極細レギュラー)×1
[一般販売予定価格 11,000円(税・送料込)]
※皆様の応援購入により量産効率が向上した場合、正規販売価格が販売予定価格より下がる可能性もございます。
※デザイン・仕様は変更になる可能性もございます。ご了承ください。
※ご注文状況、使用部材の供給状況、製造工程上の都合等により出荷時期が遅れる場合があります。
【早割15%OFF】イオン電動歯ブラシIONPA×2台【80セット限定】
18,700円(税込)
■イオン電動歯ブラシIONPA × 2台
・本体×2
・専用スタンド×2
・ブラシ(抗菌極細レギュラー)×2
[一般販売予定価格 22,000円の15%OFF(税・送料込)]
※皆様の応援購入により量産効率が向上した場合、正規販売価格が販売予定価格より下がる可能性もございます。
※デザイン・仕様は変更になる可能性もございます。ご了承ください。
※ご注文状況、使用部材の供給状況、製造工程上の都合等により出荷時期が遅れる場合があります。
【超超早割30%OFF】イオン電動歯ブラシIONPA【60台限定】
7,700円(税込)
■イオン電動歯ブラシIONPA × 1台
・本体×1
・専用スタンド×1
・ブラシ(抗菌極細レギュラー)×1
[一般販売予定価格 11,000円の30%OFF(税・送料込)]
※皆様の応援購入により量産効率が向上した場合、正規販売価格が販売予定価格より下がる可能性もございます。
※デザイン・仕様は変更になる可能性もございます。ご了承ください。
※ご注文状況、使用部材の供給状況、製造工程上の都合等により出荷時期が遅れる場合があります。
【超早割20%OFF】イオン電動歯ブラシIONPA【120台限定】
8,800円(税込)
■イオン電動歯ブラシIONPA × 1台
・本体×1
・専用スタンド×1
・ブラシ(抗菌極細レギュラー)×1
[一般販売予定価格 11,000円の20%OFF(税・送料込)]
※皆様の応援購入により量産効率が向上した場合、正規販売価格が販売予定価格より下がる可能性もございます。
※デザイン・仕様は変更になる可能性もございます。ご了承ください。
※ご注文状況、使用部材の供給状況、製造工程上の都合等により出荷時期が遅れる場合があります。
【早割10%OFF】イオン電動歯ブラシIONPA【180台限定】
9,900円(税込)
■イオン電動歯ブラシIONPA × 1台
・本体×1
・専用スタンド×1
・ブラシ(抗菌極細レギュラー)×1
[一般販売予定価格 11,000円の10%OFF(税・送料込)]
※皆様の応援購入により量産効率が向上した場合、正規販売価格が販売予定価格より下がる可能性もございます。
※デザイン・仕様は変更になる可能性もございます。ご了承ください。
※ご注文状況、使用部材の供給状況、製造工程上の都合等により出荷時期が遅れる場合があります。
【超超早割35%OFF】イオン電動歯ブラシIONPA×2台【30セット限定】
14,300円(税込)
■イオン電動歯ブラシIONPA × 2台
・本体×2
・専用スタンド×2
・ブラシ(抗菌極細レギュラー)×2
[一般販売予定価格 22,000円の35%OFF(税・送料込)]
※皆様の応援購入により量産効率が向上した場合、正規販売価格が販売予定価格より下がる可能性もございます。
※デザイン・仕様は変更になる可能性もございます。ご了承ください。
※ご注文状況、使用部材の供給状況、製造工程上の都合等により出荷時期が遅れる場合があります。
【超早割25%OFF】イオン電動歯ブラシIONPA×2台【60セット限定】
16,500円(税込)
■イオン電動歯ブラシIONPA × 2台
・本体×2
・専用スタンド×2
・ブラシ(抗菌極細レギュラー)×2
[一般販売予定価格 22,000円の25%OFF(税・送料込)]
※皆様の応援購入により量産効率が向上した場合、正規販売価格が販売予定価格より下がる可能性もございます。
※デザイン・仕様は変更になる可能性もございます。ご了承ください。
※ご注文状況、使用部材の供給状況、製造工程上の都合等により出荷時期が遅れる場合があります。
「Makuake(マクアケ)」は、実行者の想いを応援購入によって実現するアタラシイものやサービスのプラットフォームです。このページは、 プロダクトカテゴリの 「【いつもの2分が変わる】40年の技術が辿り着いた、イオン電動歯ブラシの集大成。」プロジェクト詳細ページです。